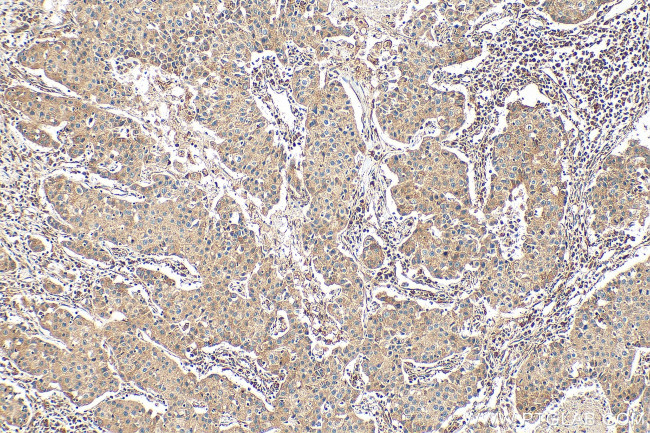
PITRM1 Antibody in Immunohistochemistry (Paraffin) (IHC (P))

Search
Proteintech
PITRM1 Polyclonal Antibody
{{$productOrderCtrl.translations['antibody.pdp.commerceCard.promotion.promotions']}}
{{$productOrderCtrl.translations['antibody.pdp.commerceCard.promotion.viewpromo']}}
{{$productOrderCtrl.translations['antibody.pdp.commerceCard.promotion.promocode']}}: {{promo.promoCode}} {{promo.promoTitle}} {{promo.promoDescription}}. {{$productOrderCtrl.translations['antibody.pdp.commerceCard.promotion.learnmore']}}
产品信息
30674-1-AP
种属反应
宿主/亚型
分类
类型
抗原
偶联物
形式
浓度
规格
纯化类型
保存液
内含物
保存条件
运输条件
产品详细信息
Immunogen sequence: ILRKLPRIKK HLLNGDNMRC SVNATPQQMP QTEKAVEDFL RSIGRSKKER RPVRPHTVEK PVPSSSGGDA HVPHGSQVIR KLVMEPTFKP WQMKTHFLMP FPVNYVGECI RTVPYTDPDH ASLKILARLM TAKFLHTEIR EKGGAYGGGA KLS
靶标信息
The protein encoded by this gene is an ATP-dependent metalloprotease that degrades post-cleavage mitochondrial transit peptides. The encoded protein binds zinc and can also degrade amyloid beta A4 protein, suggesting a possible role in Alzheimer's disease.
仅用于科研。不用于诊断过程。未经明确授权不得转售。
篇参考文献 (0)
生物信息学
蛋白别名: hPreP; metalloendoprotease; Metalloprotease 1; metalloprotease 1 (pitrilysin family); Pitrilysin metalloproteinase 1; PreP peptidasome; Presequence protease, mitochondrial; unnamed protein product
基因别名: KIAA1104; MP1; PITRM1; PREP; SCAR30
UniProt ID: (Human) Q5JRX3
Entrez Gene ID: (Human) 10531